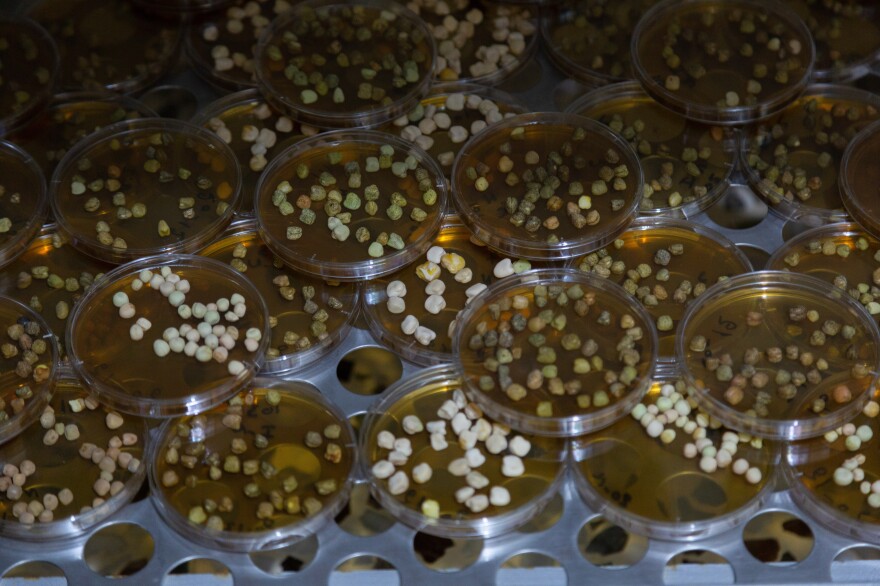
Chickpea grains are tested for various diseases at the ICARDA research station, Dec. 21, 2022.

TERBOL, Lebanon — Inside a large freezer room at the International Center for Agricultural Research in the Dry Areas, tens of thousands of seeds are stored at a constant temperature of minus-4 degrees Fahrenheit. After being threshed and cleaned, the seeds are placed inside small, sealed foil packets and stored on rows of heavy, sliding metal shelves.
Some of them may hold keys to helping the planet's food supply adapt to climate change.

The gene bank can hold as many as 120,000 varieties of plants. Many of the seeds come from crops as old as agriculture itself. They're sown by farmers in the Fertile Crescent region, where cultivation began some 11,000 years ago. Other seeds were deposited by researchers who've hiked in the past four decades through forests and mountains in the Middle East, Asia and North Africa, searching for wild relatives of wheat, legumes and other crops that are important to the human diet.
The research center, formed in the 1970s, once mostly helped farmers in poorer countries in hot, dry climates. But now it also sends seeds to scientists in Europe, Canada and the United States, helping lead to breakthroughs in improving certain crops' resilience to the effects of climate change.
"What we are collecting is a sample of the diversity that we have in nature," saysMariana Yazbek, who manages the gene bank. Yazbek calls the center an "insurance policy" for humanity — it saves seeds in case nuclear war or other catastrophic events should wipe out plant species.

The center replicates the seeds it collects by planting and harvesting them in the fields that surround it in the Bekaa valley. ICARDA then sends a copy to the Global Seed Vault, also known as the "doomsday vault," in Svalbard, Norway, an archipelago in the Arctic Ocean.
And the seeds that ICARDA — which is funded by governments and international organizations — sends to scientists around the world are used to develop new varieties of crops such as wheat that can tolerate heat and drought.
"These wild relatives of crops have been evolving on Earth for millions of years, and they witnessed so many different climates," says Yazbek. "The traits that help them adapt and survive in these conditions is stored in their DNA. We have this diversity and it can be a tool to help us face the future."
The seed bank's original home was in Syria
The wealth of genetic material in ICARDA's seed bank might have been lost if not for a dramatic rescue effort a decade ago by its employees.

The seed bank was originally housed in Syria, at a center close to Aleppo. But then civil war began in 2011, and rebels opposing the Syrian government and Islamic extremists took over parts of the country. At least one ICARDA researcher was kidnapped; others were shot at. Armed men stole the organization's flock of over 300 sheep being bred for research.
Hassan Machlab, an ICARDA country manager in Lebanon, recalls that employees were able to locate 125 of the animals by searching livestock markets and bring them across to Lebanon, where they peacefully munch hay in their stalls these days.

Raffat Azzo, a researcher with ICARDA who specializes in barley breeds, managed to save his entire collection of thousands of plant specimens as warplanes flew overhead. He hired a bus, onto which he loaded hundreds of boxes of different barley seed varieties. The journey to Lebanon involved crossing multiple front lines. "It wasn't simple," Azzo recalls. But he believes it was worth the risk. "The seeds we saved are now fighting climate change."
The seeds are helping farmers in Europe and the U.S.
After leaving Syria, ICARDA established a gene bank in Morocco as well as in Lebanon. The organization now runs centers for agricultural projects in more than a dozen other countries around the world.


In Lebanon, ICARDA is housed in a collection of low buildings with orange tiled roofs, surrounded by fields of experimental grains in the Bekaa valley. The work there continues despite the country's descent into what the World Bank calls one of the worst economic crises of modern times. The center has multiple diesel generators to keep the seed bank running during the power outages that have become a daily reality in the country.
Despite these challenges, ICARDA's Lebanon center remains an important hub.
Fouad Maalouf, a legume breeder, collaborates with scientists in more than 30 European countries including France, the U.K. and Italy. He takes the seeds ICARDA researchers collect from the wild and from local farmers and tests them for disease and crossbreeds them in experimental crops planted around the center. He then shares seeds from these plants with scientists in these countries that use their genes to develop new crops of chickpeas, lentils and other varieties of legume.


Maalouf says the scientists are particularly interested in legumes as a crop now because these plants capture a lot of carbon dioxide from the atmosphere. They also release nitrogen into the soil, meaning the farmers have to use less chemical fertilizer. And legumes take very little water to grow, he says. "So you are saving the environment, and second, you save water."
ICARDA's work is also helping farmers in the U.S.Dil Thavarajah, a professor at Clemson University, has worked with ICARDA researchers for over a decade, exploring ways to improve the nutritional qualityof lentils. One of her discoveries, using lentil seeds native to the Mediterranean sent by the organization, could even help tackle obesity. Thavarajah extracted genetic material from which her team then bred crops that contain low digestible carbohydrates, also known as prebiotic carbohydrates; these compounds help regulate a person's weight via modulating gut health.

The legume seeds also contain a particular trait that produces sugar alcohols that act as humectants, a substance that attracts and absorbs moisture and "saves the plant from freezing or saves the plant from drying out," says Thavarajah. This is important because climate change is making growing seasons more unpredictable, with more extreme swings in weather. Thavarajah says using ICARDA'S seeds she developed legumes that — for the first time — can grow in South Carolina in the winter. She says this new winter crop is now being introduced in states across the American south.
In another case, a wheat seed collected in Iran and then stored and saved from the war in Syria, has allowed scientists in the U.S. to develop new wheat varieties resistant to the Hessian fly, a pest that causes tens of millions of dollars in damage to American crops every year.
Back at the seed bank in Lebanon, Mariana Yazbek looks over the tens of thousands of collected species. A major challenge, she says, is deciding which of the seeds collected from nature and local crops to store. Then it takes years of research to identify their unique properties. She says thousands of the seeds in the gene bank remain untested.
With such a large collection in ICARDA's seed vault, Yazbek says, this is only the beginning of the help ancient grains and legumes can give farmers in a changing climate.
Copyright 2023 NPR. To see more, visit https://www.npr.org.